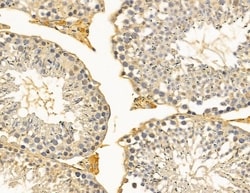
Invitrogen RBBP6 Polyclonal Antibody 100 &mu;L; Unconjugated:Antibodies,

missing translation for 'onlineSavingsMsg'
Learn More
Learn More
Invitrogen™ RBBP6 Polyclonal Antibody


Rabbit Polyclonal Antibody
Brand: Invitrogen™ PA5104100
This item is not returnable.
View return policy
Description
Antibody detects endogenous levels of total RBBP6.
This gene encodes a cilia-associated protein belonging to the kinesin family. This protein plays a role in the sonic hedgehog (SHH) signaling pathway through the regulation of GLI transcription factors. It functions as a negative regulator of the SHH pathway by preventing inappropriate activation of GLI2 in the absence of ligand, and as a positive regulator by preventing the processing of GLI3 into its repressor form. Mutations in this gene have been associated with various ciliopathies.
Specifications
| RBBP6 | |
| Polyclonal | |
| Unconjugated | |
| Rbbp6 | |
| 4933422O15Rik; AI316869; BB233631; C030034J04Rik; C77662; E3 ubiquitin-protein ligase RBBP6; im:7158869; MY038; my038-like; P2PR; P2P-R; p53-associated cellular protein of testis; PACT; Proliferation potential-related protein; protein P2P-R; RB binding protein 6, ubiquitin ligase; RB-binding Q-protein 1; Rbbp6; rbbp6l; RBQ1; RBQ-1; retinoblastoma binding protein 6; retinoblastoma-binding protein 6; retinoblastoma-binding protein 6, isoform 3; retinoblastoma-binding Q protein 1; RING-type E3 ubiquitin transferase RBBP6; SNAMA | |
| Rabbit | |
| Affinity Chromatography | |
| RUO | |
| 19647, 5930 | |
| -20°C | |
| Liquid |
| Immunohistochemistry (Paraffin), Western Blot | |
| 1 mg/mL | |
| PBS with 50% glycerol and 0.02% sodium azide; pH 7.4 | |
| P97868, Q7Z6E9 | |
| Rbbp6 | |
| A synthesized peptide derived from human RBBP6(Accession Q7Z6E9), corresponding to amino acid residues F1440-E1490. | |
| 100 μL | |
| Primary | |
| Human, Mouse | |
| Antibody | |
| IgG |
Product Content Correction
Your input is important to us. Please complete this form to provide feedback related to the content on this product.
Product Title
Spot an opportunity for improvement?Share a Content Correction